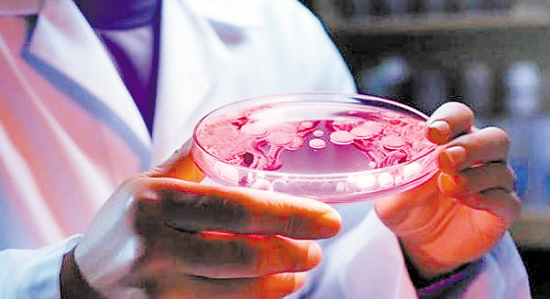

近日发表在国际学术期刊《微生物学前沿》上的一项新研究显示,在罗马尼亚一处数千年历史的冰洞中发现的一种古老细菌对多种现代常用抗生素具有耐药性,表明细菌的耐药性可以在自然演化中形成。
这种细菌发现于罗马尼亚一处冰洞约5000年前形成的冰层中。罗马尼亚科学院布加勒斯特生物研究所等机构的研究人员在冰洞中钻取了一根长25米的冰芯,从中分离出多种细菌菌株,并对它们的基因组测序分析,以研究其耐寒机制以及耐药性相关基因等。
研究人员利用10大类的28种临床常用或储备用抗生素对其中一种名为SC65A.3的嗜冷菌菌株进行测试,发现它对其中的10种抗生素表现出耐药性,包括利福平、万古霉素和环丙沙星等用于治疗常见感染的药物。

